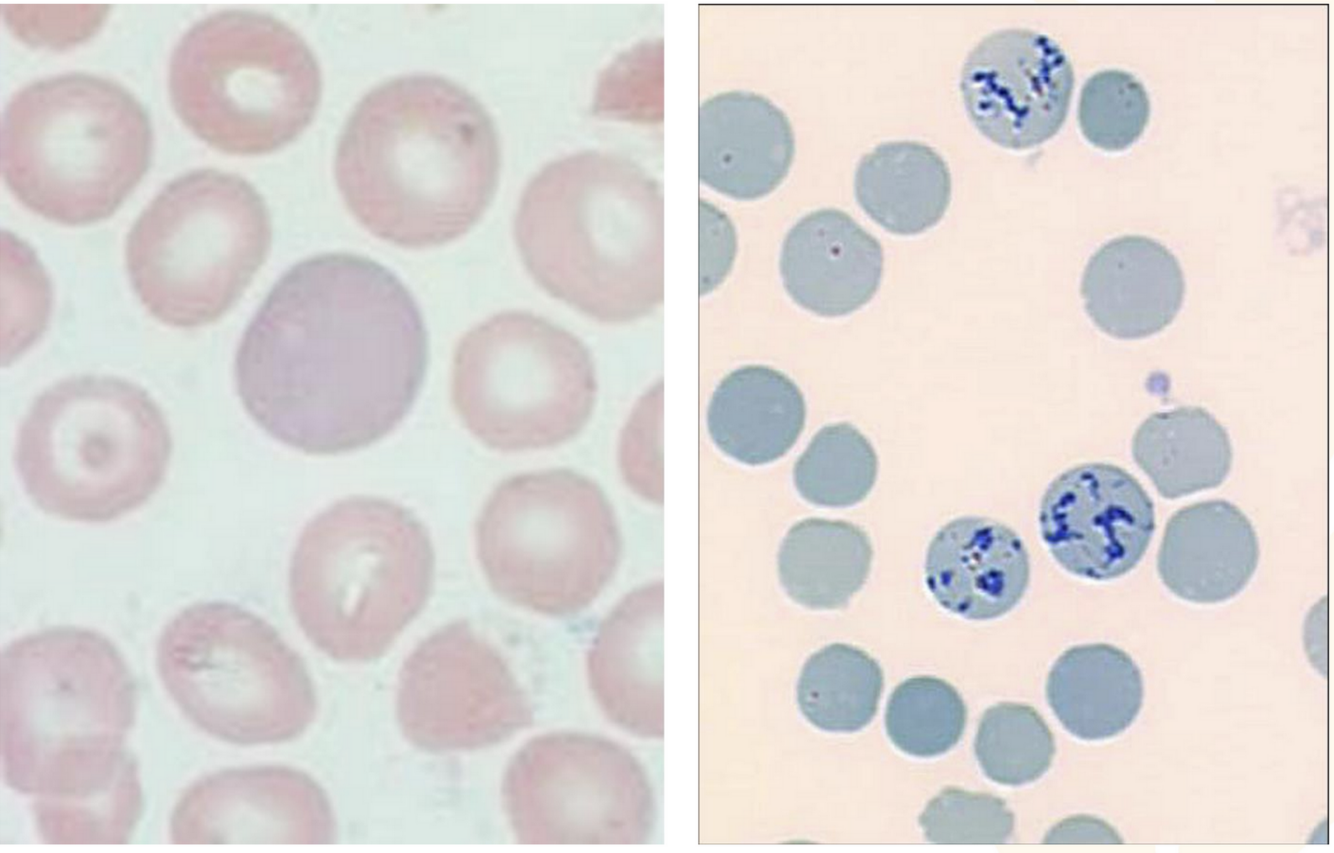

blood volume and composition
- Normally 5-6 liters
- Fluid (55%) and cellular (45%) components
- Fluid component = Plasma (water, proteins, solutes)
Serum (clotted plasma) - Cellular Component
Erythroid (43-44%)
Buffy coat (leukocytes and platelets, 1-2%)

difference btw plasma and serum: serum is plasma that has components which allow clotting
erythryocytes (RBCs) overview
- 7-8 μm diameter (< lymphocyte nucleus)
- Biconcave disc
- Round with central area of pallor (1/3 diameter)
- Anucleate
- Eosinophilic cytoplasm (hemoglobin)
- Simple metabolism (glycolysis)
- 120 day lifespan
- Senescent cells removed by splenic macrophages

Erythrocyte Function
- Transport oxygen from the lungs to the tissues
- Transport carbon dioxide from the tissues to the lungs

Erythropoiesis - general overview
- Maturation features
1) Size (decreasing)
2) Nucleus (decreasing size, increasing chromatin
density, extrusion of nucleus)
3) Cytoplasm (increasing eosinophilia = hemoglobin) - Stages of maturation
- Regulation by erythropoietin
maturation features - size and nucleus relationship
cell size and nucleus size (decreasing) with maturation

Nucleus (decreasing size, increasing chromatin
density, extrusion of nucleus) with maturation
maturation features - size and nucleus
Nucleus (decreasing size, increasing chromatin
density, extrusion of nucleus) with maturation
cell size decreases with maturation

reticulocytes vs mature erythrocytes
Cytoplasm (increasing eosinophilia = hemoglobin)
both pictures below are reticulocytes
measurement of reticulocytes is important in anemia - anemia causes release of immature reticulocytes to compensate* Lipid bilayer (phospholipids, cholesterol)
Fluidity inversely proportional to cholesterol content
- Proteins
- Carbohydrate (glycolipids, glycoproteins)
Erythropoiesis regulation by erythropoietin
The main factor regulating erythroid proliferation is erythropoietin (EPO), a 34-kD glycoprotein growth
factor, which is produced by interstitial peritubular cells of the kidney in response to hypoxia.
Tissue hypoxia leads to upregulation of hypoxia-inducible transcription factors, which in turn control
EPO production. EPO affects erythroid precursors at all stages of development and influences erythroid
lineage commitment, proliferation, and differentiation, as well as iron uptake and metabolism by red
cell precursors.

Erythrocyte Membrane
- Lipid bilayer (phospholipids, cholesterol)
Fluidity inversely proportional to cholesterol content - Proteins
- Carbohydrate (glycolipids, glycoproteins)

Erythrocyte Cytoskeleton
- Network of contractile proteins (deformability, shape)
- Attach to the cell membrane
- Spectrin (α and β chains, form heterodimers)
- Other proteins (actin, tropomyosin, band 4.1,
ankyrin, glycophorins) - Horizontal vs. vertical interactions

Hemoglobin
- Tetrameric molecule
- Heme component (iron binding)
- Globin chains
Heme Synthesis
- Mitochondria vs. cytoplasm
-mitochondria: initial and final steps
-intermediate steps in cytoplasm - Synthetic pathway
- Clinical correlation:
- Ringed sideroblasts
- Lead poisoning
- Porphyrias
heme synthesis - Mitochondria vs. cytoplasm
-mitochondria: initial and final steps
-intermediate steps in cytoplasm

ferrous iron (II)
synthetic pathway for heme synthesis (simplified version) and heme synthesis - clinical correlation, porphyrias

heme synthesis - clinical correlation, lead poisoning
blocks incoporation of iron at the protoporphyrin 9 stage causing image to the right referred to as basophilic stippling where rna fragments precipitate

heme synthesis - clinical correlation, ringed sideroblasts
red cell precursors in the bone marrow with an iron stain
blue granules form around the nucleus in the image below
iron (blue) would usually be incorporated into the porphyrin ring but is blocked creating ringed sideroblasts

Globin Chain Synthesis
*Genes on chromosomes 16 and 11
*Pairs of α and non-α globin chains
*α chains: α (adult) and ζ (embryonic)
*Non-α chains: β (adult), δ (adult), γ (fetal), and ε
(embryonic)

Normal Hemoglobins
*Adult: A (α2β2), A2 (α2δ2)
*Fetal: F (α2γ2)
*Embryonic:
Gower 1 (ζ2ε2), Gower 2 (α2ε2), and Portland (ζ2γ2)

Hemoglobin Function
- 4 heme, four globin (2 pair), 4 iron (Fe++), 4 oxygen
- Ability to bind oxygen depends on conformation
(successive binding becomes easier) - Hemoglobin-oxygen dissociation curve
- Right shift (acidosis, increased temperature,
increased 2,3-DPG) - Left shift (alkalosis, decreased temperature,
decreased 2,3-DPG, hemoglobin F, carbon monoxide)

Hemoglobin-oxygen dissociation curve
- Right shift (acidosis, increased temperature,
increased 2,3-BPG) - Left shift (alkalosis, decreased temperature,
decreased 2,3-BPG, hemoglobin F, carbon monoxide)

Erythrocyte Energy Metabolism
- Glycolysis (anaerobic) – 2 ATP (net) per glucose
- Hexose monophosphate shunt (G6PD)
Reduction reactions (free radicals)
Methemoglobin (Fe+++) – Heinz bodies - Rapoport-Luebering shunt
Generation of 2,3-bisphosphoglyerate (2,3-bPG)
more bpg, shift curve right, lower affinity for O2
Hexose monophosphate shunt (G6PD)
Reduction reactions (free radicals)
Methemoglobin (Fe+++) – Heinz bodies

Erythrocyte Senescence
- 120 day lifespan
- Splenic macrophages
-recognize ageing/deformed red cells and remove them - Catabolism and recycling of hemoglobin components:
Iron
Heme (bilirubin)
Globin chains
Heme recycling (bilirubin)
The heme portion of the hemoglobin molecule undergoes a series of reactions, which
initially result in the formation of biliverdin, which is subsequently converted to bilirubin. This bilirubin
is referred to as unconjugated (indirect) and is not soluble in water. Unconjugated bilirubin is released
into circulation and bound to albumin, which transports it to the hepatocytes for additional processing.
In the hepatocytes, bilirubin is conjugated with glucuronic acid and becomes water soluble. Conjugated
(direct) bilirubin can then be excreted in bile into the small intestine. Much (95%) of the excreted
bilirubin is reabsorbed within the small intestine and returned to the liver via the enterohepatic
circulation. The non-reabsorbed bilirubin may be metabolized to urobilinogen by colonic bacteria.
Urobilinogen may be subsequently oxidized to form urobilin and stercobilin, which are excreted and
give fecal material its brown color. Some of the reabsorbed urobilinogen is excreted by the kidneys and
further oxidized to urobilin, which imparts a yellowish color to urine. In pathologic conditions
associated with increased erythrocyte destruction (hemolysis), elevated levels of some of the products
of heme catabolism can be detected in the blood and urine. The hemoglobin synthesis and catabolism
pathways are summarized in the figure below.



